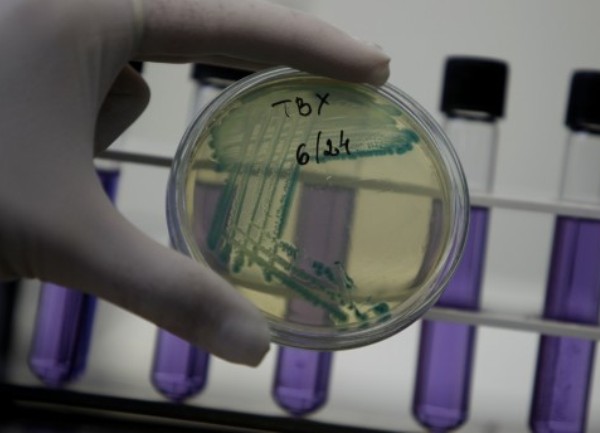
adepantin

Antibiotici ubijaju bakterije, ne i viruse. Virusi, kod kojih su antibiotici nemoćni, uzrokuju 9 od 10 upala grla te gripu.
No, ljudi imaju naviku sami sebi prepisivati lijekove. Upravo zato Svjetska zdravstvena organizacija (WHO) u svom najnovijem izvješću upozorava kako nepotrebno uzimanje antibiotika smanjuje njihovu djelotvornost u slučajevima infekcija za koje su namijenjeni, budući da bakterije s vremenom razvijaju otpornost na antibiotike, javlja Index.
WHO stoga savjetuje - antibiotike uzimajte samo onda kad vam ih liječnik prepiše jer su vam nužni! U suprotnom, pomažete stvaranju supervirusa i superbakterija.
"Otkako su prije 70 godina otkriveni, antibiotici su većinu nas održali na životu pomažući nam da prebolimo bakterijske infekcije koje bi u suprotnom mogle biti fatalne.
Antibiotici su nam, u prosjeku, produžili životni vijek za oko 20 godina", kaže Zsuzsanna Jakab, regionalna direktorica WHO za Europu, te dodaje: "Ako želimo očuvati ovo medicinsko čudo, onda moramo shvaćati kad antibiotici djeluju, a kad ne, i tako se i ponašati".
(DEPO/BLIN/em)
PODIJELI NA
Depo.ba pratite putem društvenih mreža Twitter i Facebook